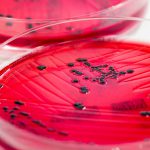
Muslim body to file review against SC Babri ruling

Gujarat 2002: Judges legitimized Hindu supremacy instead of dispensing justice
Even as the RSS leader admired Hitler’s crimes against Jews, he also favored Jews forcibly occupying Palestine
Hindutva Pop: Mixing dance tracks with calls for religious warfare
Mixing dance tracks with calls for religious warfare, Hindutva pop amplifies a wave of Hindu nationalism in Narendra Modi’s India.
Hindu Temple Triumphs in Babri Masjid Mosque Case
India’s Supreme Court on Saturday ruled in favor of a Hindu temple on a disputed religious ground in the country’s north and ordered that...
India’s BJP wants citizenship bill to counter mistakes in Assam’s NRC
Assamese groups are against the final version of the citizens' list that excludes indigenous and Hindu communities. Now, New Delhi wants to introduce a citizenship bill to save "genuine" residents from deportation.
VHP, Modi, Narasimha Rao’s roles in Ayodhya land title case
By Niharika Sharma
Twenty-seven years after the Babri mosque at Ayodhya in the northern Indian state of Uttar Pradesh, was demolished, the Indian supreme court has given...
India draws the line on Kashmir
On 2 November, the Government of India’s Press Information Bureau released two maps that show all of the former (but contested) princely state of...
Former Supreme Court Judge slams Babri order
The Supreme Court announced its final verdict in the contentious Ayodhya case on November 9, less than a month after it concluded final hearing...
Muslim body to file review against SC Babri ruling
Paul Krugman
Transformation of India is nearly complete: New York Times
According to Indian journalist Hartosh Singh, the Indian Supreme Court’s decision to allow the building of a temple for Rama on a disputed site is likely to intensify the Hindu nationalist efforts to turn India into a majoritarian nation.
Court Backs Hindus on Ayodhya, Handing Modi Victory in His Bid to Remake India
NEW DELHI — India’s Supreme Court ruled in favor of Hindus on Saturday in a decades-old dispute over a holy site contested by Muslims,...
Babri Masjid Judgement
Supreme Court prefers faith over law in bias against Muslims
RSS
Exposing the hypocrisy on secularism and Hindu Rashtra
Essentials of Hindutva
Savarkar’s hate-filled tract set Hindu Rashtra’s agenda